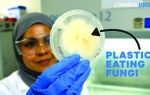

Loại gạo đắt nhất hành tinh

Đây là sản phẩm của Hợp tác xã nông nghiệp Toyo Rice, được sản xuất và thu hoạch thủ công từ 5 loại gạo từng đoạt giải cao nhất ở Nhật Bản
Sách Kỷ lục Guinness Thế giới vừa ghi danh loại gạo đắt nhất thế giới do Nhật Bản sản xuất, có tên Kinmemai Premium.
Đây là sản phẩm của Hợp tác xã nông nghiệp Toyo Rice, được sản xuất và thu hoạch thủ công từ 5 loại gạo từng đoạt giải cao nhất ở quốc gia này. Sau đó, gạo được ủ hương vị trong 6 tháng bằng công nghệ đánh bóng hạt độc quyền do Toyo Rice phát triển cách đây hơn 17 năm.
Kinmemai Premium được cho là có giá trị dinh dưỡng và hương vị vượt trội so với các loại gạo thông thường. Nó có hương vị hạt dẻ đặc trưng mà không giống gạo nào có. Do được đánh bóng bằng kỹ nghệ độc quyền nên nó trông giống như những viên kim cương nhỏ xíu hơn là hạt gạo, chỉ loại bỏ lớp cám không ăn được.
Theo Toyo Rice, gạo Kinmemai Premium có giá trị dinh dưỡng vượt trội, nó có chứa lipopolysaccharides, hợp chất tăng cường hệ miễn dịch tự nhiên giúp duy trì sức khỏe và chống bệnh tật nhiều gấp 6 lần so với gạo trắng thông thường.
Ngoài ra, KP còn có nhiều chất xơ hơn 1,8 lần và nhiều vitamin B1 hơn 7 lần so với các loại gạo thông thường. Không cần vo, gạo vẫn mang hương thơm và vị ngọt độc đáo. Được quảng cáo là "ngon nhất hành tinh", KP được thương phẩm theo gói 140 gram, với giá khoảng 120 USD/kg (tương đương gần 3 triệu đồng/kg).
Theo Toyo Rice, lạm phát đã đẩy giá gạo lên cao nên dự báo, giá gạo KP có thể còn tăng trong tương lai.